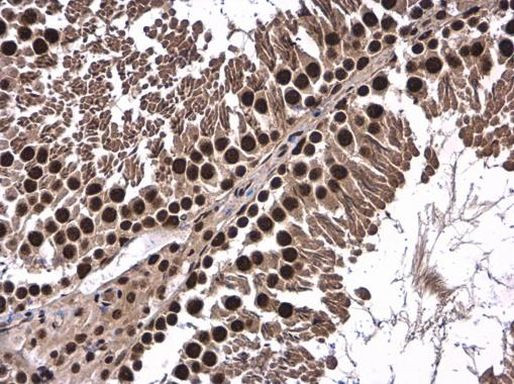
FUBP3 Antibody in Immunohistochemistry (Paraffin) (IHC (P))
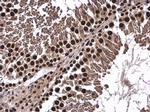
FUBP3 Antibody in Immunohistochemistry (Paraffin) (IHC (P))

Search
Invitrogen
FUBP3 Polyclonal Antibody
{{$productOrderCtrl.translations['antibody.pdp.commerceCard.promotion.promotions']}}
{{$productOrderCtrl.translations['antibody.pdp.commerceCard.promotion.viewpromo']}}
{{$productOrderCtrl.translations['antibody.pdp.commerceCard.promotion.promocode']}}: {{promo.promoCode}} {{promo.promoTitle}} {{promo.promoDescription}}. {{$productOrderCtrl.translations['antibody.pdp.commerceCard.promotion.learnmore']}}
产品信息
PA5-30547
宿主/亚型
分类
类型
抗原
偶联物
形式
浓度
规格
保存条件
运输条件
RRID
产品详细信息
Recommended positive controls: NT2D1, IMR32, U87-MG, MCF-7.
Predicted reactivity: Mouse (96%), Rat (97%), Zebrafish (81%), Xenopus laevis (90%), Pig (95%), Chicken (91%), Rhesus Monkey (100%), Bovine (95%).
Store product as a concentrated solution. Centrifuge briefly prior to opening the vial.
靶标信息
May interact with single-stranded DNA from the far-upstream element (FUSE). May activate gene expression.
⚠WARNING: This product can expose you to chemicals including mercury, which is known to the State of California to cause birth defects or other reproductive harm. For more information go to www.P65Warnings.ca.gov.
仅用于科研。不用于诊断过程。未经明确授权不得转售。